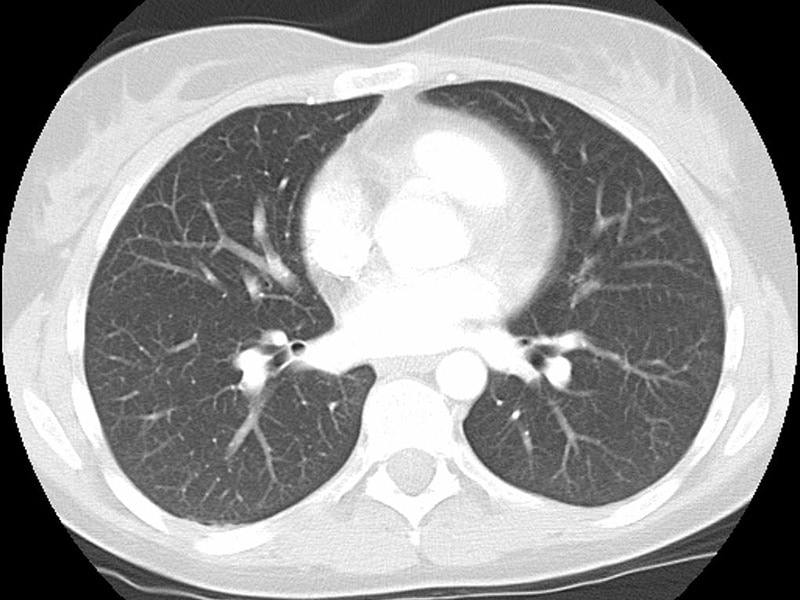

If you guys also searching about An arteriogram was performed and reveal a systemic arterial supply to you've came to the great page. We also have 13 Pictures about An arteriogram was performed and reveal a systemic arterial supply to like Pulmonary Roundtable: Follow-up to abnormal CxR, Emphysema – CT - Radiology at St. Vincent's University Hospital and We also haveCT of the Lung in Children: Clinical Applications | Radiology Key. Here it is:
An Arteriogram Was Performed And Reveal A Systemic Arterial Supply To
sequestration pulmonary ct
The Radiology Assistant : Basic Interpretation

hrct radiology lung nodular disease nodules interstitial pulmonary lungs mri
Lung Ct - Thorax CTs - Embodi3D.com

lung ct file embodi3d
Emphysema – CT - Radiology At St. Vincent's University Hospital
emphysema ct radiology
Shared Decision 'Virtually Absent' In Lung Cancer Screen Chat
normal
CT Of The Lung In Children: Clinical Applications | Radiology Key

lung ct clinical applications children fig
Xrays And CT Scans Of Lung Cancer
lung xrays abnormal
Segmental Atelectasis | Radiology Reference Article | Radiopaedia.org

atelectasis radiopaedia segmental radiology
Pulmonary Roundtable: Follow-up To Abnormal CxR

abnormal 2005 cxr follow ct lung pulmonary roundtable collapsed november
Challenges In Pulmonary Fibrosis · 3: Cystic Lung Disease | Thorax
lung interstitial fibrosis pulmonary cystic thorax bmj
SVC Syndrome Due To Small Cell Lung Cancer - Chest Case Studies
ct chest ctisus svc cancer lung syndrome cell studies diagnosis case
Ventilatory Management Of Acute Lung Injury And Acute Respiratory
jama journals lung jamanetwork
Image | Radiopaedia.org

follicular bronchiolitis ct radiopaedia radiology
Abnormal 2005 cxr follow ct lung pulmonary roundtable collapsed november. Atelectasis radiopaedia segmental radiology. Lung xrays abnormal
Comments
Post a Comment